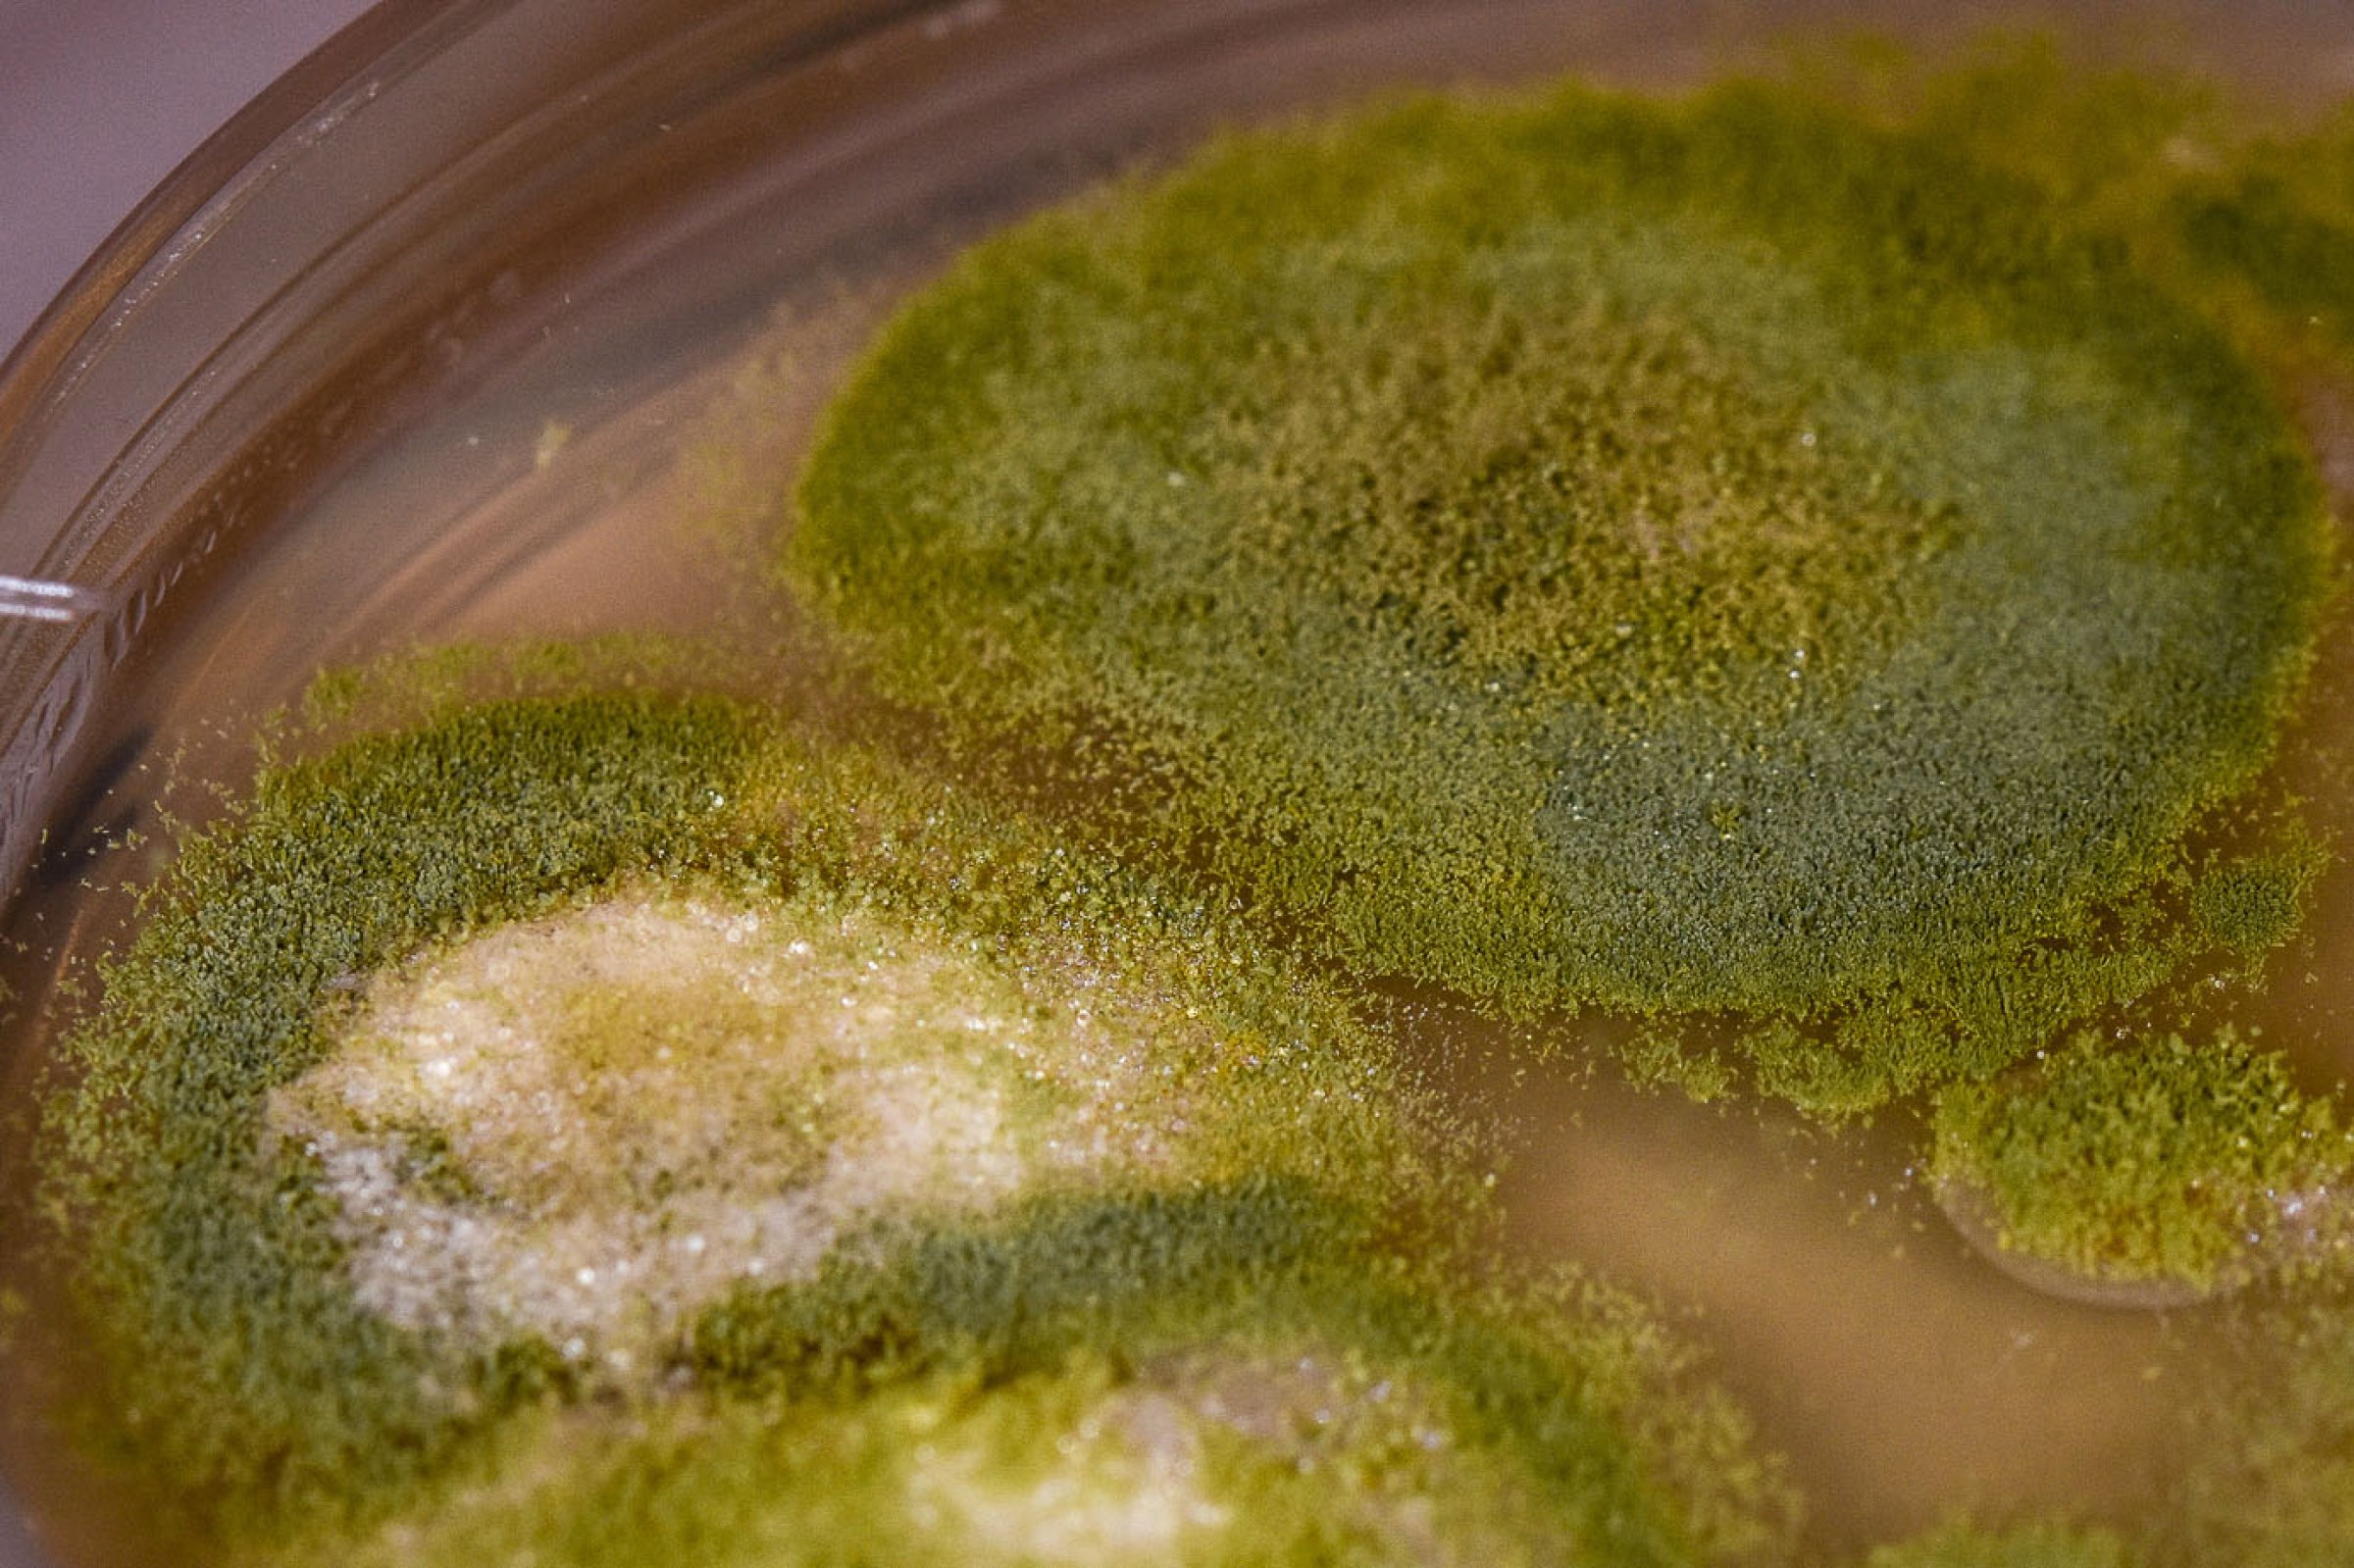

Aspergillose
Aspergillus er en muggsoppslekt som er vidt utbredt over hele verden som saprofytter i miljøet (jord, luft, vann, støv, planter, kompost). Noen arter er opportunistisk patogene for mennesker og dyr og flere arter kan produsere mykotoksiner (soppgifter).
Aspergillus-arter produserer store mengder sporer som lett spres via luft. Sporene kan inneholde allergener og har derfor også potensiale til å kunne forårsake allergi og astma. Aspergillus som sykdomsfremkallende agens får stadig økt betydning.
Aspergillose er en fellesbetegnelse på sykdomstilstander forårsaket av muggsopp i slekten Aspergillus.
Smittestoff og smitteveier
Det er først og fremst Aspergillus fumigatus som er årsak til aspergillose, men også A. flavus, A. niger, A. nidulans, A. terreus m. fl. forekommer. Disse artene er varmekjære og har evnen til å germinere og vokse godt ved kroppstemperatur eller høyere (37-48 °C) noe som gjør de til effektive patogener. A. fumigatus er også sterkt angioinvasiv (vokser inn i blodkar) og kan ved hematogen spredning gi infeksjon i nær sagt alle organer. Vanligste smittevei er via luftveier, men også via mage/tarm etter inntak av muggent fôr.
Inhalasjon av aspergillussporer er en vanlig, dagligdags affære. Normale slimhinner og et friskt immunapparat vil vanligvis klare å fjerne sporene som inhaleres, og ingen infeksjon eller symptomer vil oppstå. Hos individer med nedsatt immunforsvar (pga. sykdom eller medisiner) kan sporene lettere germinere og resultere i kolonisering og invasjon av vev. Individer med astma og allergi kan også være mer utsatt for aspergillusinfeksjoner. Massiv eksponering, dårlig fôr, dårlig ventilasjon, støvete miljø, kronisk stress mm er også faktorer som øker risikoen for infeksjon og allergi.
Aspergillus og toksiner
Flere arter av Aspergillus kan produsere mykotoksiner (soppgifter) som er helseskadelige for både dyr og mennesker. Blant disse er aflatoksin det mest kjente, og produseres av artene A. flavus og A. parasitticus. Aflatoksin er først og fremst levertoksisk (leversvikt, leverkreft) og immunotoksisk. Vanligste kilde til forgiftning er via næringsmidler som nøtter (peanøtter, paranøtter, pistasjnøtter, hasselnøtter), fiken og mais.
Andre mykotoksiner og sekundære metabolitter (f.eks gliotoksin) regnes som en viktig virulensfaktor hos Aspergillus, for å undertrykke immunapparatet og dermed øke infeksjonsevnen til soppen. Det er også kjent at gliotoksin og tremorgener er toksiske for blant annet storfe. Blant annet surfôr som er kontaminert med Aspergillus kan inneholde slike stoffer.
Sykdomstegn og diagnostikk
Aspergillose er primært en luftveisinfeksjon, men som kan generalisere og infisere nær sagt alle vev og organer. Vevspreferanser kan imidlertid variere en god del fra art til art. De vanligste formene for aspergillose hos dyr er; luftsekk- og lungeinfeksjon hos fugler, sinonasale infeksjoner hos hund og katt, luftsekkmykose hos hest og mykotisk abort hos storfe.
Symptomer ved allergisk aspergillose kan være tungpustethet, hoste, bronkitt og forverring av astmaproblemer.
Ved nekrose og granulomer bør invasiv soppinfeksjon alltid være med som en differensialdiagnose.
Fugler er de dyra som er aller mest utsatt for aspergillose. Både viltlevende fugler og tamfugler/fjørfe som holdes av mennesker. Infeksjonen ses primært i lunger og luftsekker. Mykotisk trakeitt er også beskrevet. Spredning til hjernen er ikke uvanlig. Aspergillose hos fjørfe kan opptre i en akutt eller kronisk form. Akutt aspergillose ses oftest hos høne- og kalkunkyllinger og kan resultere i høy morbiditet og mortalitet. Kronisk aspergillose opptrer hos voksne fugler og blir ofte ikke oppdaget før slakting.
Særlig i kalkunbesetninger kan mortaliteten bli svært høy med store økonomiske tap.
Symptomer kan være pustebesvær, sløvhet, anoreksi, avmagring. Gule noduler (av varierende størrelse og konsistens) og plakk kan sees i lunger, luftsekker og slimhinner. Pelsliknende vekst av sopp kan observeres i luftsekkene.
Hos hunder er aspergillose typisk lokalisert i nesehulen og/eller paranasale sinuser (bihuler). Sinonasal aspergillose (SNA) sees hovedsakelig hos hunder med lang og middels lang nese (hhv dolichocepahle og mesocephale raser). Gjerne unge aktive hunder uten forutgående sykehistorie eller underliggende sykdom. Typiske symptomer er kronisk rennende nese fra ett eller begge nesebor, ofte pusstilblandet eller blodig. Andre symptomer kan være nysing, smerter ved palpasjon, depgimentering av snuten, ulcerasjon (sår) på nesevinger. Ved rhinoskopi vil man kunne se et hvitt belegg (plakk) og/eller osteaktige masser inne i nesehulen, og oppspiste nasoturbinalier (nekrose). Ved røntgen eller CT (computertomografi) vil det ofte være synlig tap av bentetthet.
Disseminert aspergillose (dvs. spredning til andre organer) ses hovedsakelig hos immunsuprimerte hunder. Det er oftest sett hos middelaldrende tisper og schäferhund ser ut til å være predisponert. I de fleste tilfeller skjer infeksjonen via øvre luftveier etterfulgt av hematogen spredning til andre organer; oftest til nyrer, milt og ryggvirvler (spondylitt), men det er også sett spredning til lymfeknuter (i bryst og buk), benvev, lever, hjerte, lunger, øyne og nær sagt alle andre organer. Symptomer på disseminert aspergillose kan være sløvhet, anoreksi, vekttap, ryggsmerter, halthet, muskeltap, feber, hematuri, urininkontinens, generalisert lymfadenopati og neurologiske symptomer.
Aspergillus som sekundær årsak til øreinfeksjon er sett hos hunder som har stått på langvarige antibiotikakurer.
Ved mykose i luftsekkene (utposninger av svelgslimhinnen) hos hest er neseblødning og svelgebesvær vanlige komplikasjoner. Den infiserte luftsekk er karakterisert med nekrotiserende inflammasjon med en fortykket, blodig slimhinne dekket av en sprø pseudomembran. Mykotisk rhinitt karakterisert av dyspne (tung pust) og neseflod er også beskrevet hos hest. Ved infeksjon i lungene kan aspergillose ha et raskt dødelig forløp. Akutt enteritt kan ofte være en predisponerende faktor i slike tilfeller. Kolitt er antatt å resultere i betydelig nøytropeni (redusert antall nøytrofile granulocytter/hvite blodceller) som reduserer immunkompetansen til individet, fulgt av invasjon av Aspergillus fra en ødelagt tarmslimhinne. Dersom infeksjonen spres til hjerne og synsnerve kan bevegelses- og synsforstyrrelser (inkludert blindhet) opptre.
Hos drøvtyggere kan aspergillose forårsake bronkopneumoni, gastroenteritt, mastitt, placentitt og abort. Mykotisk pneumoni kan ha et raskt forløp med dødelig utgang. Symptomer vil være feber, rask/overflatisk/snorkende respirasjon, rennende nese og fuktig hoste. Lungene vil være faste, tunge, flekkete og kollapser ikke. Ved subakutt eller kronisk mykotisk pneumoni inneholder lungene multiple granulomer og sykdommen kan minne mye om tuberkulose.
Ved gastroenteritt er det oftest bladmagen (omasum) som er affisert. Pneumoni og placentitt kan ofte være sekundære infeksjoner til hematogen spredning fra primære gastrointestinale lesjoner.
I fravær av pneumoni og gastroenteritt kan det eneste symptomet være abort i 6-9 måned (av og til tidligere). Lesjoner finnes i uterus, fosterhinner og ofte i fosterets hud. Tilbakeholdt etterbyrd er en vanlig følgetilstand.
Hos katter sees aspergillose oftest i nese og bihuler (sinonasal og sinoorbital). Sammenlignet med hund er aspergillose hos katt sjelden forekommende. Brachycephale raser ser ut til å være mest disponert. Sinonasal infeksjon opptrer omtrent som hos hund med kronisk rennende nese (pusstilblandet eller blodig), ofte fra kun ett nesebor. Ytterst i neseborene kan det være inflammasjon og ulcerasjon (små sår). Sinoorbital infeksjon kan være svært aggressiv, og forårsaker ofte betydelig hevelse og skjevhet i ansiktet. I noen tilfeller kan det sees en masse i fossa pterygopalatina eller ulcerasjon av den harde gane. Disseminert/systemisk aspergillose sees i sjeldne tilfeller. De vanligste stedene for infeksjon er benvev og mellomvirvelskiver i ryggen med halthet, sløvhet og ustøhet som vanlig symptomer. Andre symptomer kan være, feber, vekttap, matvegring og uveitt. CNS kan også invaderes og forårsake neurologiske symptomer.
Aspergillus flavus (og noen flere arter) er kjent for å kunne infisere honningbier og forårsake det som kalles steinyngel hos både larver og voksne bier. Infiserte og døde larver omdannes til steinharde mumier. Voksne bier mister flygeevnen og bakkroppen mumifiseres. Honning fra angrepne bisamfunn kan inneholde aflatoksin. Steinyngel er klassifisert som en meldepliktig Liste 2-sykdom. Det er en sjelden forekommende sykdom, men som er påvist over store deler av verden, men erforeløpig ikke påvist i Norge.
Prøvetaking og diagnostikk
Ved mistanke om aspergillose bør det sendes inn prøver for dyrking. Ved infeksjon i luftveier er svaber og skylleprøve aktuelt. Ved dype og systemiske infeksjoner vil biopsier, kroppsvæsker og sekreter, organ- og vevsprøver være aktuelt prøvemateriale. Ved mistanke om mykotisk abort er fosterets mageinnhold det beste materiale.
En diagnose bør imidlertid sjelden basere seg på dyrking alene. Aspergillus er allestedsnærværende og kan isoleres fra luftveier også hos friske individer og kan lett opptre som en kontaminant i ikke-sterilt prøvemateriale. Andre diagnostiske undersøkelser som bildediagnostikk, endoskopi, histologi, cytologi, serologi bør vurderes for å understøtte diagnosen.
Forekomst
Betydningen av aspergillose hos dyr og mennesker har økt over de siste tiårene. Aspergillus er vidt utbredt over hele verden og finnes overalt i miljøet. Det finnes ca. 200 ulike arter, men kun noen få av disse er opportunistisk patogene. Aspergillose er påvist hos mennesker og nesten alle domestiserte dyr og fugler så vel som i mange ville arter. Det kan opptre på mange ulike vis, alt fra lokale infeksjoner til dødelig disseminert sykdom så vel som allergisk respons ved inhalering av sporer. Hos dyr er aspergillose først og fremst en luftveisinfeksjon, men som kan generalisere til andre organer. Vevspreferanser kan imidlertid variere mye fra art til art. Vertsfaktorer og miljøfaktorer er viktig for utvikling av infeksjon. Individer med nedsatt immunforsvar er særlig utsatt.
Tiltak
Aspergillose hos produksjonsdyr (fjørfe og storfe) behandles normalt ikke. Hos sports og familiedyr kan soppdrepende midler som enten gis topikalt eller systemisk (oralt eller intravenøst). Azolederivater og amphotericin B er de vanligst brukte medikamentene. Der det er mulig vil kirurgisk fjerning av infisert vev i kombinasjon med systemisk behandling som regel øke sannsynligheten for vellykket behandling.
Hos hund med SNA (sinonasal aspergillose) er det flere behandlingsalternativer. Trepanering (åpning av sinuser) og deponering av klotrimazol via frontalsinus er den mest anvendte metoden. Med eller uten debridering i form av fjerning av aspergillusmasser, plakk og nekrotisk vev.
Tidlig diagnose og behandling er avgjørende for prognosen. Førstevalg ved behandling er azoler. Aspergillus fumigatus er normalt følsom, men azoleresistens forekommer i økende grad.